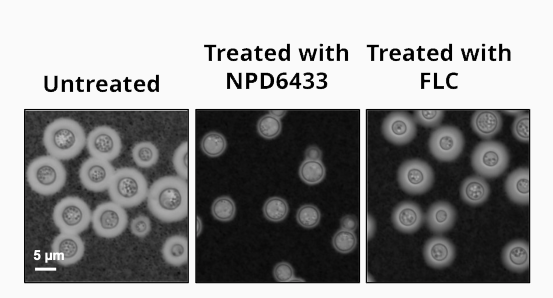
images of fungal growth in three conditions

Aug. 3, 2023 Press Release Biology
Deadly fungus beaten with new type of treatment
Researchers at the RIKEN Center for Sustainable Research Science (CSRS) and the University of Toronto have discovered a new way to attack fungal infections. The key is to block fungi from being able to make fatty acids, the major component of fats. Resistance to anti-fungal drugs is increasing and this new approach will be particularly useful because it works in a new way and affects a broad range of fungal species. The study was published in the scientific journal Cell Chemical Biology.
Most of us are familiar with athlete’s foot, a relatively harmless health issue that can be solved by a trip to the drug store. But other fungal infections are more serious, and the Candida, Cryptococcus, and Aspergillus types of fungus are responsible for millions of deaths every year. Like bacterial resistance to antibiotics, fungal resistance to medications is also growing worldwide, and the death toll will likely rise in the near future unless something is done now.
Currently there are only three major classes of anti-fungal medications, and all of them work by destroying the barrier that surrounds fungal cells. Paradoxically, even though they all attack the barrier, current treatments are actually very specific, meaning that what kills one species of fungus might not kill another.
The group of researchers wanted to find another way to combat harmful fungi, one that would be useful against numerous species. Their approach was to first screen the structurally-diverse RIKEN natural product depository (NPDepo) against four pathogenic yeasts—three Candida and one Cryptococcus species—which have been identified as critical human pathogens by the World Health Organization. They were looking for something that would affect all four species, which would indicate that it might be effective against a broad range of fungi.
The screening identified several compounds that reduced fungal growth by at least 50% in each of the four species, and after eliminating ones which were already known, the researchers were left with three new possibilities. Among these three, the one least toxic to human cells also reduced growth of Aspergillus fumigatus, an extremely common fungal mold that is deadly to immuno-compromised individuals. The name given to this compound in the RIKEN NPDepo is NPD6433. The next step was to find out what it does.
For almost 1000 different genes, the researchers looked at how much NPD6433 suppressed growth in yeast when the yeast was missing one copy of the gene. They found that reduction in only one gene, fatty acid synthase, made yeast more susceptible to NPD6433. This result meant that NPD6433 likely works by inhibiting fatty acid synthase and thus prevents fatty acids from being made inside fungal cells. Further experiments showed that NPD6433 and cerulenin, another fatty acid synthase inhibitor, were able to kill numerous yeast species in culture.
The final experiment tested how well NPD6433 treatment worked in a live laboratory model organism—the worm Caenorhabditis elegans—which was infected with a pathogenic yeast that can cause systemic infection in humans after invading through the intestines. C. elegans was chosen because it has an intestinal tract that works like ours. Tests showed that treating infected worms with NPD6433 reduced fatalities by about 50%. Importantly, this was true in worms infected with yeast that were resistant to a standard anti-fungal medication.
“Drug-resistant fungi are a growing problem, and leads for the development of new drugs offer hope against these evolving pathogens,” says Yoko Yashiroda, lead RIKEN CSRS author of the study. “Our research indicates that targeting fatty acid synthesis is a promising alternative therapeutic strategy for fungal infections, and one which might not require tailor-made solutions for individual species.”
Rate this article
Reference
Contact
Yoko Yashiroda, Deputy Team Leader
Charles Boone, Team Leader
Molecular Ligand Target Research Team
RIKEN Center for Sustainable Resource Science
Adam Phillips
RIKEN International Affairs Division
Tel: +81-(0)48-462-1225
Email: adam.phillips [at] riken.jp
A fungus (C. neoformans) grown in three conditions: untreated, treated with a sub-lethal dose of the fatty acid synthase inhibitor NPD6433, and treated with a fluconazole. The number and virulence of fungi were reduced with NPD6433 treatment.
